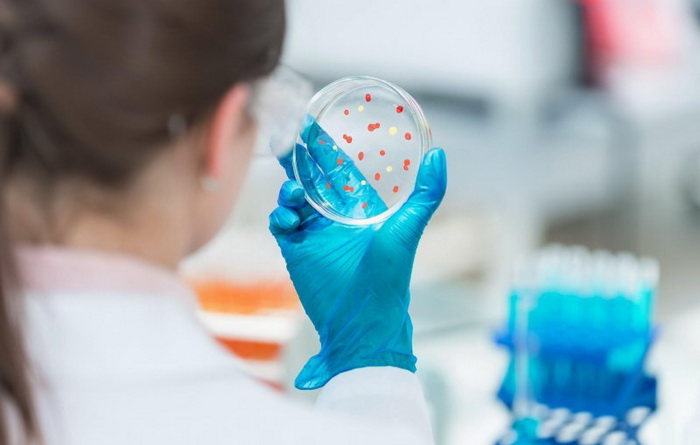
Ruski lijek protiv koronavirusa će biti registrovan ove godine

Svijet
Indija: Najmanje 10 poginulih u požaru u covid klinici
Najmanje 10 ljudi poginulo je u požaru u privatnoj klinici u kojoj se liječe i pacijenti oboljeli od covida 19 u Indiji.
Svijet
Čudno je da ruski hakeri nisu krivi za Bidenove padove
Čudno je da ruski hakeri nisu krivi što je predsjednik SAD Joe Biden tri puta pao na stepenicama aviona, porokomentarisala je portparol ruskog Ministarstva spoljnih poslova Marija Zaharova.
BiH
Maass: Nominacija 'Aide' pravda za sramotnu Nobelovu nagradu negatoru genocida
Američki novinar Peter Maass nije krio svoje oduševljenje nominacijom bh. filma "Quo vadis, Aida", rediteljice Jasmile Žbanić, za prestižnu nagradu Oscar.
Svijet
Srušio se avion u Kazahstanu
Vojni transportni avion "antonov An-26" srušio se u gradu Almati u Kazahstanu, saopštio je Aerodrom u Almatiju.
Politika
Palmer prenio Čoviću jasan stav SAD, suprotan željama HDZ-a
Specijalni predstavnik SAD-a za Zapadni Balkan Matthew Palmer razgovarao je danas sa dopredsjedavajućim Doma naroda Parlamentarne skupštine BiH i predsjednikom HDZ-a BiH Draganom Čovićem.
KORONAVIRUS
U RS stiže 20.000 doza ruskih vakcina
U Republiku Srpsku danas stiže 20.000 doza ruskih vakcina Sputnjik, potvrđeno je za RTRS.
Svijet
Srušio se vojni helikopter u Turskoj, više osoba poginulo
Vojni helikopter se srušio na istoku Turske.
Kultura
Izložba plakata 'Free Patrick Zaki' otvorena u galeriji MAK
Izložba plakata “Free Patrick Zaki” otvorena je večeras u galeriji MAK Muzeja književnosti i pozorišne umjetnosti BiH, a u okviru 37. Festivala Sarajevska zima.
Kultura
Izložba 'Free Patrick Zaki' danas u galeriji 'Mak'
Izložba "Free Patrick Zaki" bit će otvorena danas u galeriji "Mak" Muzeja književnosti i pozorišne umjetnosti BiH, a u okviru 37. Festivala "Sarajevska zima".
Svijet
Egipat oslobodio novinara Al Jazeere Mahmouda Husseina
Mediji i izvori za ljudska prava u Egiptu i Kataru objavili su u četvrtak navečer da su egipatske vlasti pustile novinara Al Jazeere Mahmouda Husseina.
BiH
Zbog godišnjice stradanja na Markalama GRAS mijenja trasu kretanja
KJKP Gradski saobraćaj obavještava korisnike da će, u skladu sa Rješenjem Ministarstva saobraćaja Kantona Sarajevo, a zbog obilježavanja godišnjice stradanja građana Sarajeva na pijaci Markale u petak, 5.februara od 11.30 do 12.00 sati doći do izmjene javnog gradskog prijevoza.